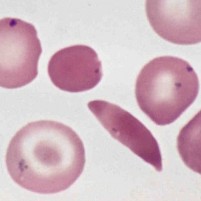

Base substitution mutation
Sickle cell disease is used as an example of a base substitution mutation. Students build on the basic vocabulary and apply their understanding to an IB style question about the consequences of a base substitution leading to sickle cell anaemia. This is an introduction to alleles. A structured worksheet helps students to keep their notes clear. The last activity contains three further IB style questions which give students an opportunity to improve their exam technique by improving typical student responses.
Lesson Description
Guiding Questions
How does a single DNA base change cause the creation of a new allele?
What effect does a single base change in a gene have on a cell?
Activity 1 Sickle Cell Activity
Diagnosed with sickle cell disease, Shaniya strives to be a normal teenager, one not defined by her disease.
Watch this
Living with sickle cell disease video as an introduction to Sickle cell disease.
This NCBI Genome Database entry shows the HBB gene which carries the mutation in Sickle cell disease.
Which chromosome is it on, what is the 'Gene locus'?
Explore the genetic cause of this disease by completing the
Sickle Cell base substitution activity
on the worksheet below.
Activity 2 Improving Answers in IB Exam Questions
The worksheet above should illustrates how a single base mutation can cause a disease. However, using these facts in IB exams under exam conditions is not easy.
This activity helps to practise using these simple points in more difficult exam question settings.
Note the different command terms Define, Discuss, Describe and Explain.
In fifteen minutes, write answers to the questions below.
Then compare your results with the model answers and suggested mark schemes.
1. Describe the consequences of a gene mutation with respect to sickle cell disease.
(4 marks)
2. Explain how Sickle cell disease can be caused by a gene mutation.
(4 marks)
3. Discuss the possible harmful effects and the potential benefits of a gene mutation
(6 marks)
Here is an example of some typical student responses. How do your answers compare?
1. Describe the consequences of a gene mutation with respect to sickle cell disease.
A Gene Mutation -> altered mRNA after transcription -> change to amino acid sequence -> this changes the shape of the haemoglobin.
2. Explain how Sickle cell disease can be caused by a gene mutation.
A Gene Mutation is a mutation in a single gene, a base can be deleted.
This causes the DNA codon to be altered.
The structure of the protein is not the same as usual
and the person has Sickle cell anaemia
3. Discuss the possible harmful effects and the potential benefits of a gene mutation
A Gene Mutation which has harmful effects is the mutation which causes sickle cell disease.
It can also have a benefit that it protects the sufferer from malaria.
The harmful effects are a change to the shame of red blood cells caused by a change in the red blood molecule.
This is a suggested exam answer mark scheme. How many of the points did you include?
1. Describe the consequences of a gene mutation with respect to sickle cell disease.
DEFINITION
A mutation is a change in DNA sequence;
SEQUENTIAL STEPS IN THE PROCESS
This mutation changes the mRNA made by transcription;
It changes the amino acids in the protein made;
It is a base substitution mutation / changes to one codon;
ANOTHER DETAIL
Amino acid Glu, glutamic acid, is changed to Val, valine / GAG to GTG;
FINAL CONSEQUENCE
this changes the shape / function of hemoglobin / red blood cells form a sickle shape;
sickle cell anemia caused by two mutated recessive alleles;
2. Explain how Sickle cell disease can be caused by a gene mutation.
STEP 1 - STARTING POINT
one codon/base in the DNA/gene is altered;
STEP 2 - EFFECT
mRNA made from the DNA has one altered base/codon;
GAG becomes GUG in mRNA / CTC becomes CAC in DNA / GAG becomes GTG in DNA;
STEP 3 - CONSEQUENCE
a different amino acid inserted into the polypeptide/protein;
valine is inserted into the protein in the place of glutamic acid;
STEP 4 - OUTCOME
the structure of the polypeptide/protein is altered;
the altered hemoglobin may cause red cells to become sickle shaped;
3. Discuss the possible harmful effects and the potential benefits of a gene mutation
FIRST CLAIM / ONE SIDE OF DISCUSSION
example of a harmful gene mutation
e.g. base substitution in sickle cell anaemia;
possible harmful effect; e.g. sickle cell disease
detail of possible harmful effect; e.g. change in the structure of haemoglobin
another possible harmful effect; e.g. red blood cells have a sickle shape
detail of another possible harmful effect; e.g. RBCs get stuck in capillaries.
COUNTERCLAIM / THE OPPOSITE POINT OF VIEW
potential benefit of a gene mutation e.g. resistance to malaria in Sickle Cell Trait (heterozygous)
another possible harmful effect; e.g. malaria parasite is unable to reproduce in RBCs
Extra Reading:
This video
Sickle cell disease is a great animation of the causes of the disease from Academia de Ciência e Tecnologia de São José do Rio Preto in Brazil. Chapter 1, 2 and 4 are relevant for IB Biology students although details of hemoglobin are covered in the Option D only.
Select the promoter and polymerase enzyme to Express a gene in DNA to produce a Protein (Animation from PhET)
Explore Beneficial mutations in humans - The Big Think
Find out more about Specific human genetic disorders - Human genome research institute
Teachers notes
The idea first is to catch student interest with the video of Shaniya's story living with sickle cell disease in the USA. To explain how a gene causes a disease the first activity uses a simple worksheet to structure an explanation of the role of base substitution mutation in cystic fibrosis. It revises protein synthesis and DNA, mRNA structure too.
There are some model answers on this page:
The second activity gives students a chance to apply this new knowledge and to practise some exam skills.
It is designed for projection during a lesson so the mark scheme and the example students answers can be displayed at relevant points during the lesson. Some students may prefer to look at the student answers and write improvements, others may prefer to dive straight into the exam questions themselves. It is possible to use the resources for either approach.
Further information
- The new Wellcome Trust website. Your Genome - in the cell
- An explanation of gene expression
- Facts about the central dogma and transcription and translation
- Interactive Human Genome: Inside your DNA - Genome Explorer Can you find the gene for sickle cell disease?
IB Docs (2) Team